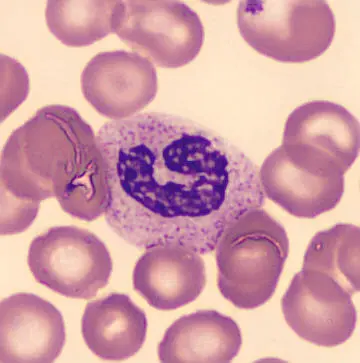
Light microscopic image of a neutrophil in a blood smear.

A balanced iron metabolism is an essential prerequisite for our health. Drugs that target iron deficiency or iron excess are among the most widely prescribed therapies worldwide. The fact that iron is an indispensable component of the blood is almost common knowledge: The metal is an important component of the blood pigment hemoglobin, which is responsible for transporting oxygen in the red blood cells.
The iron supply to the cells is controlled by the two proteins IRP-1 and IRP-2. If the cell lacks iron, IRP-1 and IRP-2 crank up the production of the various iron transporter proteins that take iron into the cell. IRP-1 and IRP-2 also ensure that an equally dangerous excess of iron does not occur.
IRP-1 and IRP-2 are essential for survival: mice lacking both control proteins during embryonic development die while still in the womb. But what happens when IRP-1 and IRP-2 fail in adult mice? A team led by Bruno Galy at DKFZ has now investigated this in mice whose IRP production can be shut down by injecting a drug.
As the researchers had expected, the most striking change after IRPs were switched off was a pronounced decrease in red blood cells. Due to the lack of hemoglobin, these erythrocytes reached only a minimal size.
However, the researchers were surprised to see that white blood cells also decreased extremely. Closer examination revealed that this decline was mainly due to a deficiency of neutrophils. These immune cells account for up to two-thirds of white blood cells in humans and are an important component of the innate immune system.
This decline is not a caused by a mass death of neutrophils, but a developmental blockade in the hematopoietic system: the precursor cells in the bone marrow no longer develop into mature neutrophils, as this differentiation process is apparently iron-dependent. Other types of white blood cells, such as monocytes, were not affected by the IRP-dependent developmental blockade.
Iron limitation is a double-edged sword
“This strong iron dependence of neutrophils was previously unknown. It possibly affects the immune defense against bacterial pathogens,“ says Bruno Galy. Interestingly, on the other hand, iron deficiency is one of the body's defense strategies in bacterial infections: many pathogens are dependent on iron. To slow down their multiplication, the body hoards the metal in certain cells that serve as a storage chamber to make it more difficult for pathogens to access this valuable resource.
Another publication in the same issue of the Journal „Science Advances“*, in which Galy is also involved, demonstrates that iron deficiency in blood serum, as typically occurs with infections, leads to a decrease in neutrophils in mice and limits the ability of these immune cells to fight bacteria. “Iron deficiency apparently modulates the innate immune system. It suppresses the maturation of neutrophils and also throttles their defensive power,“ says Bruno Galy, adding: “The limitation of available iron is apparently a double-edged sword: On the one hand, the body thereby prevents bacteria from spreading. On the other hand, the function of an important arm of the innate immune system suffers.“
Not only infections but also inflammations often lead to iron deficiency and thus to anemia. Cancer patients whose disease is accompanied by chronic inflammatory conditions are therefore often affected by anemia, which can severely limit their quality of life. “Next, we want to investigate whether iron deficiency in chronic inflammation also impairs immune function,“ Galy says.
Michael Bonadonna, Sandro Altamura Elisabeth Tybl, Gael Palais, Maria Qatato, Maria Polycarpou-Schwarz, Martin Schneider, Christina Kalk, Wibke Rüdiger, Alina Ertl, Natasha Anstee, Ruzhica Bogeska, Dominic Helm, Michael D. Milsom, Bruno Galy: Iron regulatory protein (IRP-)mediated iron homeostasis is critical for neutrophil development and differentiation in the bone marrow.
Science Advances 2022, DOI: https://doi.org/10.1126/sciadv.abq4469
* Joe N. Frost, Sarah K. Wideman, Alexandra E. Preston, Megan R Teh, Zhichao Ai, Lihui Wang, Amy Cross, Natasha White, Yavuz Yazicioglu, Michael Bonadonna, Alexander J. Clarke, Andrew E. Armitage, Bruno Galy, Irina A. Udalova, Hal Drakesmith: Plasma iron controls neutrophil production and function
Science Advances 2022, DOI: https://doi.org/10.1126/sciadv.abq5384